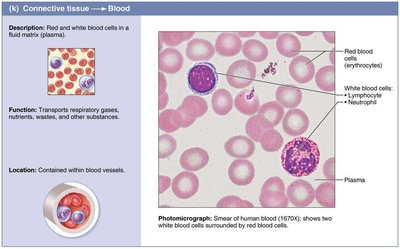
Blood tissue

Back
BackChapter 4: Tissues – The Living Fabric (Connective, Muscle, Nervous, and Membranes)
Study Guide - Smart Notes

Connective Tissue
Overview and Functions
Connective tissue is the most abundant and widely distributed of the primary tissues in the human body. It plays crucial roles in binding and supporting other tissues, protecting organs, insulating the body, storing reserve fuel, and transporting substances such as blood.
Four main classes: Connective tissue proper, cartilage, bone, and blood.
Major functions: Binding/support, protection, insulation, energy storage, and transport.
Common Characteristics
Connective tissues differ from other primary tissues by:
Varying degrees of vascularity (e.g., cartilage is avascular, bone is highly vascularized).
Cells suspended/embedded in an extracellular matrix (ECM) composed of protein-sugar mesh.
Matrix supports cells, enabling them to bear weight, withstand tension, and endure abuse.
Structural Elements
All connective tissues have three main elements:
Ground substance: Unstructured material filling the space between cells.
Fibers: Collagen (strength), elastic (stretch/recoil), and reticular (support/give).
Cells: "Blast" cells (immature, matrix-secreting), "Cyte" cells (mature, matrix-maintaining), adipocytes, white blood cells, mast cells, and macrophages.

Types of Connective Tissue Proper
Loose connective tissues: Areolar, adipose, reticular.
Dense connective tissues: Dense regular, dense irregular, elastic.
Areolar Connective Tissue
Areolar tissue is the most widely distributed connective tissue, serving as a universal packing material between other tissues. It supports and binds tissues, contains fibroblasts, and acts as a water reservoir.
Location: Under epithelia, forms lamina propria of mucous membranes.
Function: Wraps/cushions organs, holds interstitial fluid, involved in inflammation.

Adipose Tissue
Adipose tissue stores nutrients and provides insulation and shock absorption. It is richly vascularized and consists mainly of adipocytes.
Location: Under skin, around kidneys, eyeballs, within abdomen, breasts.
Function: Energy storage, insulation, protection.

Reticular Connective Tissue
Reticular tissue forms a soft internal skeleton (stroma) that supports other cell types in lymphoid organs.
Location: Lymph nodes, bone marrow, spleen.
Function: Supports blood cells, forms stroma.

Dense Regular Connective Tissue
Dense regular tissue consists of closely packed collagen fibers running parallel to the direction of pull, providing high tensile strength.
Location: Tendons, ligaments, aponeuroses.
Function: Attaches muscles to bones or muscles, withstands pulling force.

Dense Irregular Connective Tissue
Dense irregular tissue has thicker, irregularly arranged collagen bundles, forming sheets that resist tension from multiple directions.
Location: Dermis, fibrous joint capsules, organ coverings.
Function: Structural strength, resists tension.

Elastic Connective Tissue
Elastic tissue contains a high proportion of elastic fibers, allowing tissues to recoil after stretching.
Location: Walls of large arteries, certain ligaments, bronchial tubes.
Function: Maintains pulsatile flow, allows recoil.

Cartilage
Cartilage is a tough yet flexible tissue lacking nerve fibers and is avascular. It is secreted by chondroblasts and maintained by chondrocytes in lacunae.
Types: Hyaline, elastic, fibrocartilage.
Hyaline Cartilage
Most abundant cartilage, provides support and flexibility.
Location: Ends of long bones, nose, trachea, larynx, ribs.

Elastic Cartilage
Similar to hyaline but with more elastic fibers, allowing great flexibility.
Location: External ear, epiglottis.

Fibrocartilage
Intermediate properties between hyaline and dense regular tissue; strong and able to absorb compressive shock.
Location: Intervertebral discs, knee meniscus.

Bone (Osseous Tissue)
Bone supports and protects body structures, stores fat, and synthesizes blood cells. It contains more collagen than cartilage and has inorganic calcium salts.
Location: Bones throughout the body.
Function: Support, protection, blood cell formation.

Blood
Blood is a fluid connective tissue consisting of cells surrounded by plasma. It transports nutrients, wastes, gases, and other substances.
Location: Contained within blood vessels.
Function: Transport, immune response, clotting.
Muscle Tissue
Overview
Muscle tissue is highly vascularized and responsible for movement. Muscle cells possess myofilaments made of actin and myosin, enabling contraction.
Types: Skeletal, cardiac, smooth.
Skeletal Muscle
Skeletal muscle is attached to bones and causes voluntary movement. Cells are long, multinucleate, and striated.
Location: Skeletal muscles attached to bones or skin.
Function: Voluntary movement, locomotion.

Cardiac Muscle
Cardiac muscle is found only in the heart, is involuntary, and has striations. Cells are branched and connected by intercalated discs.
Location: Walls of the heart.
Function: Propels blood, involuntary control.

Smooth Muscle
Smooth muscle is found in walls of hollow organs (except heart), is involuntary, and lacks striations. Cells are spindle-shaped with one nucleus.
Location: Walls of hollow organs (digestive tract, urinary bladder).
Function: Propels substances, involuntary control.

Nervous Tissue
Overview
Nervous tissue is the main component of the nervous system (brain, spinal cord, nerves) and regulates and controls body functions. It consists of neurons and supporting cells.
Neurons: Specialized cells that generate and conduct nerve impulses.
Supporting cells: Support, insulate, and protect neurons.

Covering and Lining Membranes
Overview
Membranes are composed of at least two primary tissue types: an epithelium bound to underlying connective tissue. There are three main types:
Cutaneous membrane: Skin; keratinized stratified squamous epithelium attached to connective tissue.
Mucous membrane: Lines body cavities open to exterior; moist, may secrete mucus.
Serous membrane: Lines closed ventral body cavities; simple squamous epithelium on areolar connective tissue, secretes serous fluid.
Tissue Repair
Steps in Tissue Repair
Tissue repair occurs via regeneration (restoring original function) or fibrosis (scar tissue replaces destroyed tissue, function lost).
Inflammation: Inflammatory chemicals cause blood vessel dilation and permeability, clotting occurs.

Organization: Blood clot replaced with granulation tissue, fibroblasts produce collagen, debris is phagocytized.

Regeneration and fibrosis: Scab detaches, fibrous tissue matures, epithelium thickens, scar tissue may remain.

Regenerative Capacity
High capacity: Epithelial tissues, bone, areolar connective tissue, dense irregular connective tissue, blood-forming tissue.
Moderate capacity: Smooth muscle, dense regular connective tissue.
Low capacity: Cardiac muscle, nervous tissue (brain, spinal cord).
Clinical Relevance
Scar tissue in organs can impair function, block substances, interfere with muscle contraction or nerve transmission, and cause progressive organ failure.
Type | Main Function | Location |
|---|---|---|
Areolar | Wraps/cushions organs | Under epithelia |
Adipose | Energy storage, insulation | Under skin, around organs |
Reticular | Supports blood cells | Lymphoid organs |
Dense Regular | Withstands tension | Tendons, ligaments |
Dense Irregular | Resists tension | Dermis, capsules |
Elastic | Recoil after stretch | Arteries, ligaments |
Hyaline Cartilage | Support, flexibility | Ends of bones, nose |
Elastic Cartilage | Flexibility | Ear, epiglottis |
Fibrocartilage | Shock absorption | Intervertebral discs |
Bone | Support, protection | Bones |
Blood | Transport | Blood vessels |
